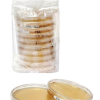

- IsoBags? eases the environmental monitoring workflow in aseptic production isolators by containing ready-to-use gamma-irradiated contact or settle plates.
- These unique transportation and packaging bags are simply mounted to the alpha port of the isolator.
- This keeps the plates available for use at any time ? and conveniently stored, taking up none of the valuable space within the isolator.
- There is no need for decontamination cycles before introducing settle or contact plates, freeing up time for your actual production processes and thus saving costs.
- The IsoBag??s operation principle allows you to standardize the transfer of environmental monitoring products into the production isolator.
- This simplifies your workflow and gives you greater flexibility, ensuring maximum safety of your products and thus of your brand.
IsoBags
In Stock
Use the filters below to view all product variations.
No items found for your selection.
- Pre-packed DPTE BetaBag® with ready-to-use single bagged contact or settle plates
- Beta port connectable to any 190 mm DPTE® Alpha port
- Complete product finally gamma-irradiated for immediate use
- Included plates traceable to corresponding batch of ICR plates
- Available with EMD Millipore TSA + LTHTh in lockable and non-lockable contact and settle plates
- Multiple connections possible
- Sterile transport bags for safe transport of
used plates included